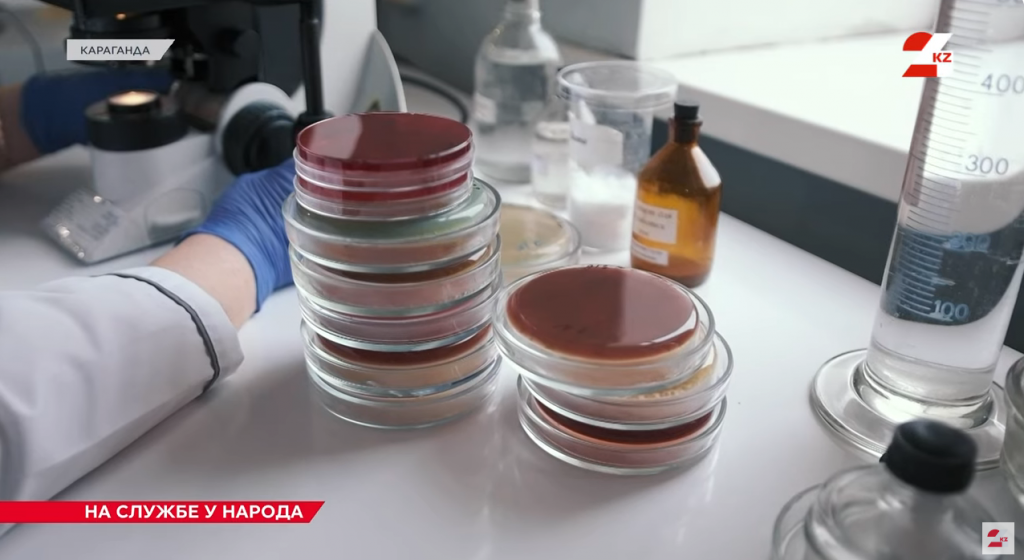
Қарағанды санитарлық қалқаны: эпидбақылау қызметі қалай жұмыс істейді

Оқиғалар лентасы
Кеше
- Жауын-шашын аз, құрғақшылық көп: 2026 жылдың шілдесі Қазақстанда қандай болады
- Қазақстанның үздік жоғары оқу орындары әлемдік рейтингтегі позициясын жоғалтты
- Қазақстанда кофе бағасы рекордтар жаңартуда
- Әлемде табиғи газ ең көп тұтынылатын жерде
- Оқуды, жұмысты немесе шетелге көшуді жоспарлап отырған қазақстандықтарға маңызды рәсім туралы еске салынды
- Көбірек бақылау және жауапкершілік: бизнесті мемлекеттік қолдау қалай өзгереді
- Бас прокуратура ұшқыштарды лазермен соқыр еткені үшін жазаны еске түсірді
- Қазақстанда балалар спортын дамытуға 50 млрд теңгеден астам қаражат жұмсалды
- Қазақстандықтарға шілде айынан бастап қандай сәлемдемелер үшін қосымша ақы төлеу керектігі айтылды
- Мүгедектігі бар адамдарды әлеуметтік қорғау саласында 500-ге жуық тексеру жүргізілді
- Қазақстанда ерекше балаларды оқытудың жаңа тәсілі пайда болды
- Автокөлік несиелеріне сұраныс төмендейді: нарықта не болып жатыр?
- Бірінші гуманоидты Робот зауыты Орталық Азияда пайда болады
- Мамыр айында Қазақстанда 147,7 мың автокөлік құралы есепке қойылды
- Ыстықта Судан басқа не ішу керек: ғалымдар күтпеген жауап берді
- ҚР фермерлері қанша ақша жұмсайды
- Мемлекет қайтыс болған әскери зейнеткерлердің отбасыларына төлемдер туралы хабарлайды
- Қазақстанға көшетіндер саны күрт азайды
- ҚР-дағы Сұлулық бағасы жаңа рекордтар жаңартты
- Қанша демалу керек: психологтың жауабы таң қалдырады
- Қазақстан трассаларының бойында электромобильдерге арналған жүздеген жаңа сервистік кешендер мен зарядтаулар пайда болады
26 маусым
- Жылу күшейеді: 27-28 маусым демалыс күндері Қарағанды мен облыста ауа райы қандай болады
- Ақша аудару лимитінен асып кеткендерге МКК-дан хаттар келді: уайымдау керек пе және қалай әрекет ету керек
- 2029 жылға қарай Қазақстандағы сапалы жұмыс орындарының үлесі 45 жетеді%
- Мерзімді несиелер есептен шығарылуы мүмкін-ARRFR
- Қазақстанда бірден төрт кодекс өзгеріске ұшырайды
- Қазақстанда электрондық сауда операторлары үшін жаңа ережелер енгізіледі
- Қазақстанда шетелдік радиоактивті қалдықтарды көмуге тыйым салынады
- Қарағандыда Семей полигонының жабылуының 35 жылдығына арналған көрме ашылады
- Бес дүркін Азия чемпионы Аделина Земс өзінің ру
- Платформалық жұмыспен қамту курьерлері үшін міндетті сақтандыру енгізілуі мүмкін
- Үлкен Михайловка ауданының тұрғындары тағы да жолсыз проблеманы көтеруде
- Демалыс күндері Орталық саябақта қарағандылықтарды бай бағдарлама күтіп тұр
- Қазақстан әуежайларындағы кафелер мен автоматтар конкурс арқылы тапсырылады
- Қазақстан мен ЕО визалық рәсімдерді оңайлату туралы келісімді бекіту кезеңіне өтті
- Бірдей тырма: Қаржы пирамидасына қалай кіруге болмайды
- Жол-көлік оқиғасынан кейін Қарағанды мамандандырылған ХҚКО "автоматта" емтихан қабылдауды уақытша тоқтатты
- Сенат психологиялық қызмет туралы заңды қолдады: не өзгереді
- Ермағанбет Бөлекпаев журналистерді кәсіби мерекелерімен құттықтады
- Қазақ операсының аңызы: Қарағандыда Ермек Серкебаевтың 100 жылдығына арналған көрме өтті
- Қарқаралыда жаңа жылдамдық өлшегіш іске қосылады
- Ежелгі бөгет пен қорғандар: Қарағанды облысында археологтар не тапты
- МҚҰ жабылғаннан кейін микрокредитпен не болады
- Ескі шиналар екінші өмірге ие болады: Теміртауда қалдықтарды қалай қайта өңдейді
- Қарағандының орталық саябағында үйрек өлгеннен кейін иттерді эвтанизацияламауға уәде берілді
- Электрондық платформа сатушыларының Қазақстанда міндеттері мен жауапкершіліктері болады
- Қарағанды облысының өңдеу өнеркәсібі шамамен 6 ға өсті%
- Қазақстандықтарға демалыс үйлерін жалға алаяқтықтың жаңа схемасы туралы ескертілді
- Қазақша сөйлеу: Қарағанды облысында ересектерге арналған Тіл лагерінің қорытындысы шығарылды
- Шартты өрт таңертең Қарағанды теміржол вокзалында сөндірілді
- Мықты идея және сенімді серіктестер: Нұрбанктің қолдауымен табыс тарихы
- Сенат мәжіліске экология мәселелері жөніндегі заң жобасын қайтарды
- Қарағанды Словакиямен серіктестігін кеңейтуде
- Қарағандыда автокөліктен ұрлық жасады деген күдікті ұсталды
- Қарағанды теміржол вокзалының жанында жолаушылар көшесінің учаскесі екі күнге жабылды
- Қарағанды облысының оқушылары республикалық Мұқағали оқуларының жүлдегерлері атанды
- Өткен мен қазіргі уақыт арасында: 26 маусым
25 маусым
- Жылу оралады: Қарағанды мен облыста 26 маусымға ауа райы болжамы
- Қазақстан су тасқынымен күресу үшін американдық технологияларды тартады
- Қазақстанда элиталық жылжымайтын мүлікке салық қалай есептеледі
- Қантты сусындарға акцизді ҚР Денсаулық сақтау министрлігі енгізуді ұсынады
- Бас жоспарларды қоғамдық талқылау ҚР да жаңа ережелер бойынша өтеді
- Асфальттың орнына қиыршық тас: Қазақстанда жолдарды жөндеудің жаңа ережелері күшіне енген кезде
- Әрбір жүзінші грант: Қазақстанда арнайы квота бойынша орындар кімге беріледі
- Қазақстанда су ресурстарының ұлттық ақпараттық жүйесі қашан іске қосылады
- Мәліметтерді ұсыну тәртібі және күдікті операциялардың белгілері нақтыланды
- Бес күн ішінде Қарағанды облысында жолаушылар тасымалы саласында 850 ден астам бұзушылық анықталды
- Қазақстанда 280-ден астам ирригациялық арналар автоматтандырылуда
- Қазақстанда дропперлер үшін қылмыстық жаза енгізілді
- ІІМ Есірткі мен күшті заттардың айналымын бақылауды күшейтеді
- Қарағанды облысындағы кент тұрғындары жаңа су құбыры іске қосылғаннан кейін проблемаларға шағымданды
- Президент: журналистер ағартушылықтың нұрын қоғамға жеткізеді
- Табысты отбасы дегеніміз не: Қазақстанда қауіпсіздікті бағалау критерийлері жаңартылды
- Қазақстандықтарға жабық схема бойынша жарыққа тарифтер көтеріледі
- Биыл ақпарат саласының 66 қызметкері пәтер кілтін алады-Тоқаев
- "Априори шындыққа жанаспайды". Қазақстандықтардан тапшылықтар мен үзілістер туралы қауесеттерге сенбеу сұралады
- Тоқаев бұқаралық ақпарат құралдары қызметкерлері күнімен құттықтады
- Қазақстанда кейбір өнеркәсіптік жобаларды қолдау шектеледі: заңға қол қойылды
- It сертификаттарын қолдан жасау әрекеттері полицияға жіберіледі
- Қарағайлы байыту фабрикасына бұзушылықтар үшін 3,5 млн айыппұл салынды
- Қазақстанда отбасының әлеуметтік әл ауқатын анықтау әдістемесі нақтыланды
- Қарағандыда Автоледи Тәттімбет көшесінің жабық учаскесіндегі бетон блокқа құлады
- Доватор көшесіндегі үйлерде субұрқақ екінші қабатқа дейін өздігінен соғылады
- Қарағандының орталық саябағында бір топ ит үйрек кемірді
- Барлық ғылыми ұйымдардың қызметкерлері 56 күн демалыс алады: Тоқаев заңға қол қойды
- Қазақстанда ересектерге қандай екпелер қажет - тегін және ақылы вакциналар тізімі
- Теміртауда Қарағанды облысының 90 жылдығына арналған картиналар көрмесі ашылады
- Қазақстанда балалар лагерлеріне лицензия алу жеңілдетілді
- Ермағанбет Бөлекпаев Қарағанды облысы тұрғындарының жеке қабылдауын өткізді
- Цифрландыру, дербес деректерді қорғау және жол қозғалысы туралы маңызды заңға Тоқаев қол қойды
- Қарағанды облыстық соты 90 жылдық мерейтойын атап өтуде
- 25 маусым: күндер, оқиғалар және қызықты фактілер
Сауалнама
Қарағандылықтар, сіз супермаркеттерде азық-түлік бағасының өскенін байқадыңыз ба?
- Әрине. Ол қазірдің өзінде қалтасын айтарлықтай ұрады;(459)
- Мен айырмашылықты сезбедім/а(1401)
Қарағанды санитарлық қалқаны: эпидбақылау қызметі қалай жұмыс істейді
Бейне Кадр
Бейне Кадр Қарағанды облысы – санитарлық қауіпсіздік ерекше маңызға ие елдің өнеркәсіптік орталығы. Су мен өнімдердің сапасынан бастап радиациялық фон мен еңбек жағдайларын бақылауға дейін мұның бәрін күн сайын аймақтың санитарлық-эпидемиологиялық қызметінің мамандары тексереді, деп хабарлайды арна 24.kz.
Олардың жұмысы көрінбейді, бірақ бұл тұрғындардың денсаулығы мен қауіпсіздігіне кепілдік береді. Бүгін біз бақылау жүйесінің қалай жұмыс істейтінін және санитарлық әл-ауқатты күзететін дәрігерлер мен зертханашылардың не істейтінін көрсетеміз.
Тақырып бойынша сілтемелерҚазақстан 2026-2035 жылдарға арналған биоалуантүрлілік Тұжырымдамасын қабылдады











 vk
vk facebook
facebook twitter
twitter ok
ok mail.ru
mail.ru instagram
instagram youtube
youtube
 Хабарландырулар
Хабарландырулар
 Ауа райы
Ауа райы Медиа
Медиа Анықтамалық
Анықтамалық













































































































